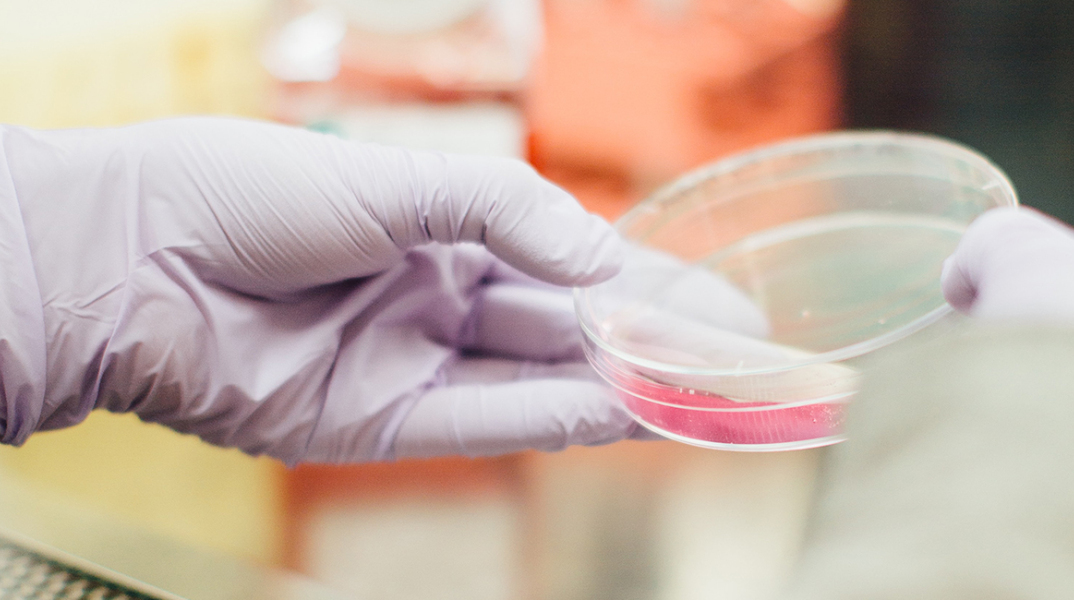
drew-hays-tgyrlchfobe-unsplash.jpg

- CITY GUIDE
- PODCAST
-
 17°
17°
Η MSD δεσμεύεται να αναπτύξει μια αποτελεσματική απάντηση στην πανδημία Covid-19 σε διεθνές επίπεδο.
Η MSD δεσμεύεται πλήρως να αναπτύξει μια αποτελεσματική απάντηση στην πανδημία Covid-19 σε διεθνές επίπεδο. Η εταιρεία ανακοίνωσε τρεις νέες σημαντικές ερευνητικές πρωτοβουλίες και συνεργασίες με στόχο την ενίσχυση της διεθνούς επιστημονικής προσπάθειας για την καταπολέμηση του νέου κορονοϊού SARS-COV-2 και την πρόληψη και θεραπεία της νόσου που προκαλείται από αυτόν, την Covid-19.
Οι ερευνητικές πρωτοβουλίες της MSD
Η MSD ανακοίνωσε την πρόθεση εξαγοράς της βιοτεχνολογικής εταιρείας Themis Bioscience, η οποία δραστηριοποιείται στην ανάπτυξη εμβολίων και ανοσορυθμιστικών θεραπειών για την αντιμετώπιση του καρκίνου και μολυσματικών ασθενειών, χρησιμοποιώντας την καινοτόμο πλατφόρμα μετάδοσης μέσω φορέα που βασίζεται στον ιό της ιλαράς. Η τεχνολογία αυτή αρχικά αναπτύχθηκε από επιστήμονες του Ινστιτούτου Παστέρ, ένα διεθνούς εμβέλειας Ευρωπαϊκό ερευνητικό ινστιτούτο και παραχωρήθηκε κατ’ αποκλειστικότητα στην Themis για την ανάπτυξη επιλεγμένων αντιικών θεραπειών. Τον Μάρτιο η Themis προσχώρησε σε συνεργασία από κοινού με το Ινστιτούτο Pasteur και το Κέντρο Έρευνας Εμβολίων του Πανεπιστημίου του Πίτσμπουργκ με την οικονομική υποστήριξη της Συμμαχίας για την Ανάπτυξη Καινοτομιών Προετοιμασίας κατά των Επιδημιών (Coalition for Epidemic Preparedness Innovations (CEPI), για την ανάπτυξη υποψηφίων εμβολίων έναντι του SARS-CoV-2 για την πρόληψη της Covid-19. Η προϋπάρχουσα συνεργασία των δύο εταιρειών θα επιταχύνει την ανάπτυξη του εμβολίου. Το πειραματικό εμβόλιο βρίσκεται στο στάδιο της προ-κλινικής ανάπτυξης και οι κλινικές μελέτες αναμένεται να ξεκινήσουν αργότερα εντός του 2020.
Τη συνεργασία με τον διεθνή Οργανισμό IAVI, ένα Μη Κερδοσκοπικό Ερευνητικό Οργανισμό, ο οποίος δραστηριοποιείται στην αντιμετώπιση παγκόσμιων προκλήσεων στο χώρο της υγείας. Η νέα συνεργασία θα στοχεύει στην κλινική ανάπτυξη ενός πειραματικού εμβολίου κατά του SARS-CoV-2 για την πρόληψη της Covid-19. Το πειραματικό αυτό εμβόλιο θα χρησιμοποιήσει την τεχνολογία που βασίζεται στον ανασυνδυασμένο ιό της φυσαλιδώδους στοματίτιδας (rVSV), που απoτέλεσε τη βάση για το εμβόλιο της MSD κατά του ιού Έμπολα του Ζαΐρ ERVEBO ® (Ebola Zaire Vaccine, Live), το οποίο είναι το πρώτο rVSV εμβόλιο που εγκρίθηκε για ανθρώπινη χρήση. Η MSD επίσης υπέγραψε συμφωνία με την Αρχή Βιοϊατρικής Προηγμένης Έρευνας και Ανάπτυξης του Υπουργείου Υγείας των ΗΠΑ για την παροχή οικονομικής υποστήριξης στα αρχικά στάδια αυτής της ερευνητικής προσπάθειας. Το υποψήφιο εμβόλιο βρίσκεται σε προ-κλινική φάση έρευνας με τις κλινικές μελέτες σε ανθρώπους να αναμένεται να ξεκινήσουν εντός του 2020.
Τη συμφωνία συνεργασίας με την εταιρεία βιοτεχνολογίας Ridgeback Biotherapeutics, για την επίσπευση της κλινικής ανάπτυξης της υποψήφιας αντιιικής θεραπείας EIDD-2801, μιας από του στόματος πειραματικής θεραπείας, που αποσκοπεί να εμποδίσει την αναπαραγωγή διαφόρων ιών RNA μεταξύ των οποίων και ο SARS-COV-2 και η οποία βρίσκεται σε αρχικά στάδια κλινικών μελετών για τη θεραπεία ασθενών με Covid-19.
Η Covid-19 είναι μια παγκόσμια πρόκληση και απαιτεί παγκόσμιες λύσεις
Με αφορμή τις νέες πρωτοβουλίες της Εταιρείας ο πρόεδρος και διευθύνων σύμβουλος της MSD, κ. Kenneth C. Frazier, δήλωσε: «Ως μια εταιρεία που διακρίνεται για την εξειδίκευση της και την ιστορία ανακαλύψεων στα εμβόλια και φάρμακα για την αντιμετώπιση Λοιμωδών Νόσων, γνωρίζουμε ότι η MSD έχει την ευθύνη να συμμετάσχει στις προσπάθειες της επιστημονικής κοινότητας για την ανεύρεση λύσεων ώστε να τερματίσει αυτή την πανδημία. Είμαστε υπερήφανοι που σηματοδοτούμε την κορύφωση της άμεσης, επιμελούς και συντονισμένης προσπάθειάς μας να εντοπίσουμε ορισμένες από τις πλέον υποσχόμενες λύσεις για αυτή την παγκόσμια πρόκληση και να διαθέσουμε τους πόρους μας για να επιταχύνουμε το αποτέλεσμά τους. Θα διασφαλίσουμε ότι όλες οι πρωτοβουλίες που ανακοινώνουμε έχουν τους πόρους, την προσοχή και προσήλωση που απαιτεί η αντιμετώπιση της πανδημίας Covid-19». Συνεχίζοντας, πρόσθεσε: «Αν και δεν μπορούμε να προβλέψουμε πότε θα κερδηθεί αυτή η μάχη, είμαστε πεπεισμένοι ότι η επιστήμη είναι στο πλευρό μας, ότι η συνεργασία είναι ήδη σε καλό στάδιο και ότι μαζί θα επικρατήσουμε απέναντι στον ιό».
ΤΑ ΠΙΟ ΔΗΜΟΦΙΛΗ

ΔΙΑΒΑΖΟΝΤΑΙ ΠΑΝΤΑ
ΔΕΙΤΕ ΕΠΙΣΗΣ
Διακρίθηκαν οι φαρμακοβιομηχανίες UNI-PHARMA και InterMed
Επόμενος σταθμός η Λήμνος
Βοηθά η άσκηση με αντιστάσεις στον περιορισμό της εξέλιξής της;
Το εύρημα που εντυπωσίασε τους επιστήμονες
Εντυπωσιακά τα αποτελέσματα
Ένα επεισόδιο για τους φόβους που μας προστατεύουν, για εκείνους (τις φοβίες) που μας φυλακίζουν και για τη στιγμή που αρχίζουμε να αναρωτιόμαστε όχι «πώς θα σταματήσω να φοβάμαι», αλλά «τι είναι αυτό που φοβάται μέσα μου;».
Νοσηλεύτρια του Ερυθρού Σταυρού εξηγεί τι τελικά ισχύει με το συγκεκριμένο ψάρι
Το ενδιαφέρον των επιστημόνων στρέφεται πλέον και στις γυναίκες που δεν θηλάζουν
Πώς οι επιπτώσεις της ακραίας ζέστης δεν περιορίζονται στην ατομική δυσφορία, αλλά επεκτείνονται στην εργασία, τη μάθηση και στην ευρύτερη λειτουργία της κοινωνίας.
Τα πρώτα συμπτώματα και οι τρόποι αντιμετώπισης
Επιπλέον, μπορούν να καταγράψουν τη βλάβη που έχει συσσωρευτεί με την πάροδο των ετών
Και αν ναι,...θέλουμε πραγματικά να σβήσουμε όσα μας πόνεσαν;
Μια συνήθεια που περνά απαρητήρητη, όμως αλλάζει πολλά
Πολλοί λένε ότι δεν τους αρέσει, άλλοι ότι δεν έχουν χρόνο και άλλοι ότι προτιμούν να κάνουν κάτι διαφορετικό
Τι προτείνουν οι ειδικοί
Συχνά διαγιγνώσκεται λανθασμένα, ενώ τα αίτιά της παραμένουν ασαφή - Πώς αντιμετωπίζεται
Η ανησυχία αυτή αποκτά ιδιαίτερη βαρύτητα καθώς η αντοχή των βακτηρίων στα αντιβιοτικά αυξάνεται διεθνώς
Επενδύοντας στη νέα γενιά ιατρών που θα διαμορφώσουν το αύριο της ιατρικής επιστήμης
Η αξία της έγκειται στη δυνατότητά της να απεικονίζει με ακρίβεια τη δομή και τη λειτουργία της καρδιάς
Έχετε δει 20 από 200 άρθρα.























































